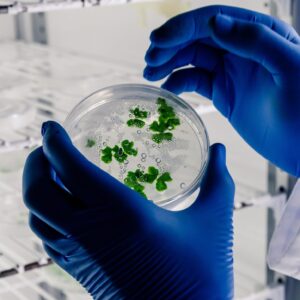
Experiencia miniPCR: Laboratorio Pea de Mendel

Filtros
-
miniPCR Detectando inocuidad de alimentos en Carritos de Comida (Food truck)
SKU: KT-1001-04$250.000 Contáctanos -
Experiencia miniPCR: Laboratorio de cazadores de microbios
SKU: KT-1401-01$115.849 Añadir al carrito -
Experiencia miniPCR: Laboratorio de aprendizaje sobre pipetas
SKU: KT-1510-10$98.201 Añadir al carrito -
Experiencia miniPCR: Laboratorio de Seguridad Alimentaria: ¡Colonia de Marte en riesgo!
SKU: KT-1001-03$146.882 Leer más -
Experiencia miniPCR: Laboratorio de diagnostico viral: Venciendo la próxima pandemia
SKU: KT-1503-01$126.194 Leer más